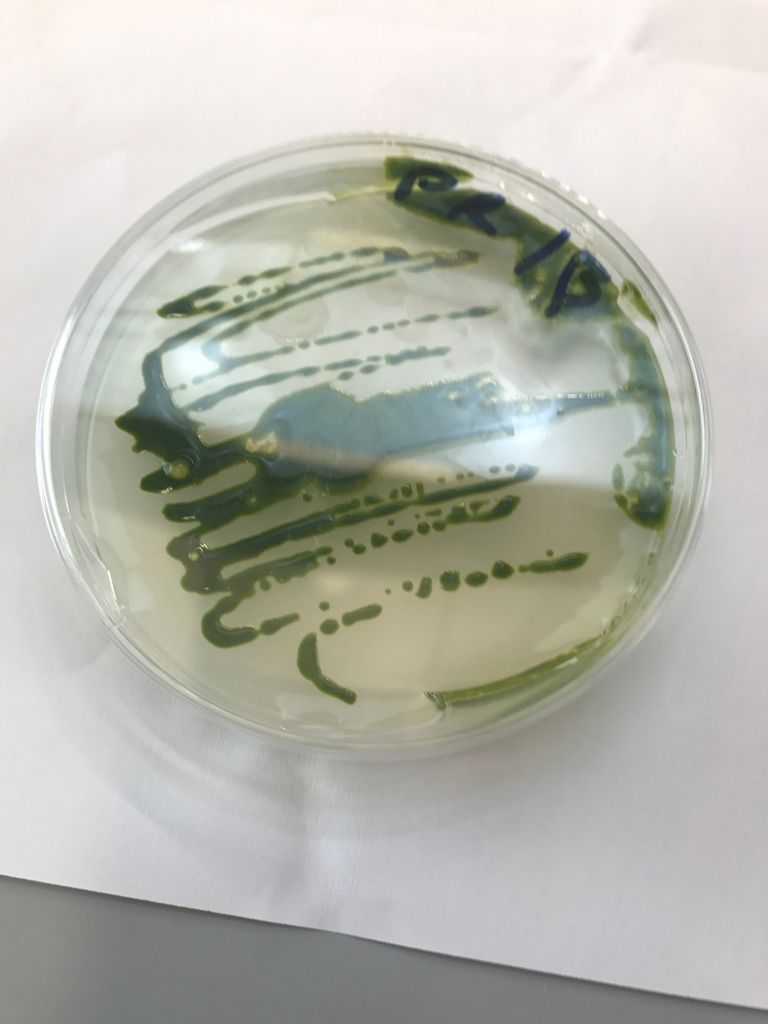
باحثون من جامعة نيويورك أبوظبي يكتشفون طحالب خضراء إماراتية

باحثو "نيويورك أبوظبي" يكتشفون نوعا فريدا للطحالب الخضراء الإماراتية
تنتمي هذه الطحالب إلى فئة الكلوريديوم وهو نوع عزل مراراً من مواقع مختلفة في الإمارات بحسب جامعة نيويورك أبوظبي.
أعلن باحثون من جامعة نيويورك أبوظبي، بالتعاون مع مجموعات أخرى من الباحثين، عن توصلهم لاكتشاف أن الصفات الجينية الفريدة للطحالب الخضراء المحلية بدولة الإمارات العربية المتحدة، والتي تمنحها قدرة البقاء على قيد الحياة في المناخ الصحراوي قد يكون لها إمكانات هامة بعيدة الأثر يمكن استخدامها في تطبيقات التكنولوجيا الحيوية.
وفي معرض تعليقه على هذا الاكتشاف، قال كوروش صالحي أشتياني، الأستاذ المشارك في علم الأحياء في جامعة نيويورك أبوظبي: "تنتمي هذه الطحالب إلى فئة الكلوريديوم، وهو نوع قمنا بعزله مراراً من مواقع مختلفة في الإمارات العربية المتحدة".
وأضاف أشتياني "أظهرت هذه الطحالب خصائص متنوعة تمكنّها من التكيّف مع المناخ المحيط بها، وذلك من خلال قدرتها على النمو في المياه العذبة وكذلك المياه ذات درجة الملوحة العالية التي تقدر بضعف ملوحة مياه البحر، بالإضافة إلى كونها قادرة على النمو عن طريق التغذية الذاتية مثل النباتات وعن طريق التكافل والتغذية العضوية مثل الفطريات أو الخلايا الحيوانية أيضاً".
وتقدم الدراسة نظرة معمّقة على التغيرات التي مرت بها هذه الطحالب لكي تنجح في التكيف والنمو في هذه المنطقة، وتخلص إلى أن الخصائص المتنوعة للطحالب تجعل من الكلوروديوم مرشحاً مثاليا للتنمية البيئية.
ومن جانبه، قال ديفيد نيلسون، عالم الأبحاث في جامعة نيويورك أبوظبي، والكاتب الرئيسي للدراسة، والتي نشرت في مجلة إي لايف العلمية: "تمتلك الطحالب الكثير من الصفات الفريدة، وتبرز من بين هذه الخصائص قدرتها على استهلاك مجموعة واسعة من مصادر الكربون، بما في ذلك السكريات المعززة، لتتمكن من تحمّل الجفاف ومراكمة وتخزين كميات كبيرة من البالميتات".
ويعزز التركيز العالي لحمض النخيل (بالمتيك) من قدرة إنتاج زيت الكلوروديوم ذو البنية العضوية المشابهة لزيت النخيل".
وبهذا الصدد، قال أشتياني: "نظراً لكونه من الزيوت ذات القيمة العالية والتي يبلغ إنتاجها العالمي حوالى 60 مليون طن متري في السنة، فقد ارتبط استخلاص زيت النخيل سابقاً بإزالة وتدمير الغابات المطرية في جميع أنحاء آسيا، الأمر الذي أثار مخاوف بيئية كبيرة مع حظر العديد من الأسواق الأوروبية استخدام زيت النخيل في منتجاتها".
وأضاف "نعتقد أن هذا النوع من الطحالب يمكن أن يوفر بعد تطويره بديلاً آمناً بيئياً لزراعة زيت النخيل، كما يمكن التوصل لفوائد تجارية وبيئية هامة كنتيجة لإجراء المزيد من الدراسات واسعة النطاق حول هذا الموضوع".
وتجدر الإشارة إلى أنه قد تم إجراء مقارنة بين الكلوروديوم وسلالات الطحالب الخضراء الأخرى، الأمر الذي كشف عن الطبيعة الاستثنائية للبيولوجيا القوية والمرنة التي تستخدمها الطحالب الخضراء من أجل النجاح في التكيّف والعيش في البيئة القاسية للسواحل الصحراوية في الإمارات العربية المتحدة، وهو الأمر الهام والجدير بإجراء المزيد من الدراسات عنه.
aXA6IDIxNi43My4yMTYuMTU4IA==
جزيرة ام اند امز